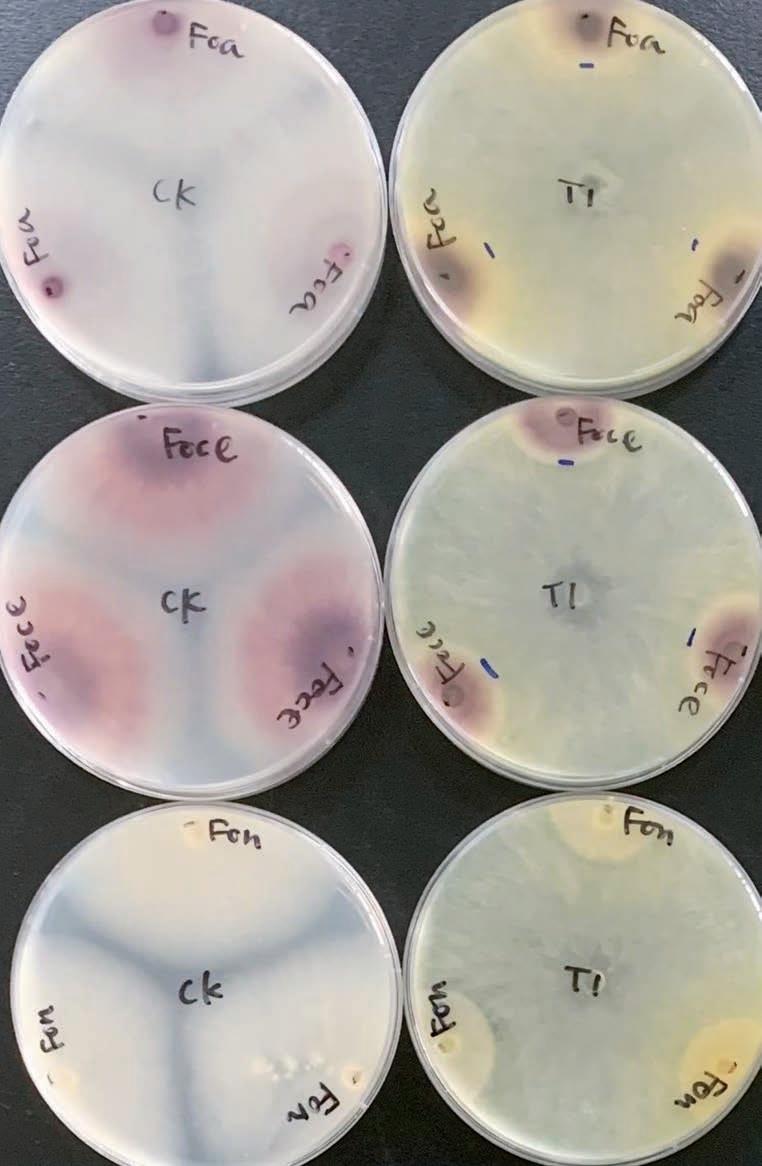

![]()


Volume 41, number 8

Researchers and onion growers come together at the 2022 annual meeting of the “Stop the Rot” research project. Find out what they’ve learned since then to help growers battle bacterial diseases of onion on page 4. Courtesy photo
2025 coming to a close means spring planting is just around the corner. Find a wide range of long-day onions to consider in the Long-Day Varieties Buyers’ Guide on pages 14-23.
PO Box 333 Roberts, Idaho 83444
Telephone: (208) 520-6461
Circulation: (503) 724-3581
OnionWorld.net
OniOn WOrld COntaCts
Editor Denise Keller editor@ColumbiaMediaGroup.com
Publisher / advertising Manager
Dave Alexander dave@ColumbiaMediaGroup.com
director of Operations
Brian Feist brian@ColumbiaMediaGroup.com
EditOrial inFOrMatiOn
Onion World is interested in newsworthy material related to onion production and marketing. Contributions from all segments of the industry are welcome. Submit news releases, new product submissions, stories and photos via email to: editor@ColumbiaMediaGroup.com.
adVErtisinG salEs
For information on rates, mechanics, deadlines, list rental, direct mail, inserts or other information, call (208) 520-6461 or email: dave@onionworld.net
sUBsCriPtiOns
U.S. $24 per year
Canada $40 per year
Foreign $80 per year
subscribe online at: www.OnionWorld.net/subscribe or call (503) 724-3581.
Email address changes/corrections to brian@ColumbiaMediaGroup.com or mail to:
Onion World PO Box 333 Roberts, ID 83444
Onion World magazine (ISSN 0892-578X), is published eight times a year and mailed under a standard rate mailing permit at Idaho Falls, Idaho and at additional mailing offices. Produced by Columbia Media Group PO Box 333, roberts, id, 83444. Copyright 2025. all rights reserved. No part of this publication may be reproduced or transmitted in any form or by any means, electronic or mechanical, for any purpose without the express written permission of Columbia Media Group. For information on reprints call (208) 520-6461.



Case studies and data collection were conducted in partnership with the University of Georgia Extension, Oregon State University, and Ag Metrics Group.










1
2
Laserweeding increased premium grade, single-center onions by 16% compared to herbicide treated onions. Location: ID/OR
36% FIRMER ONIONS
Laserweeded onions were 36% firmer than those treated with pre- and postemergent herbicides. Location: CA
3
4
45% COLOSSAL & 40% JUMBO
Laserweeding produced 53.66 tons per acre, with 45% colossal and 40% jumbo grade processing onions. Location: CA
SEEDED ONIONS IN VIDALIA
Laserweeding enabled direct seeded onions, boosting bulb diameter and weight by 200% compared to herbicide alone. Location: GA

Story and photos by Christy Hoepting, CCE Cornell Vegetable Program
The “Stop the Rot” project just wrapped up in August after six “rotten” years. It was an ambitious project involving 24 scientists from across the country who set out to research the complete system of bacterial diseases of onion to develop practical, economically sound strategies for pathogen detection and management that will improve profitability and sustainability of onion production.
Over these years, we sure did talk a lot about rot. And one thing that kept coming up was the neck part of the onion plant. Whether it was a tight neck or a soft neck, a thin neck or a thick neck, an exposed neck or a protected neck, a green neck or a dry neck, or a long neck or a short neck, focusing on the neck part of the onion plant proved to be central to managing bacterial onion bulb rot.

Soilborne bacterial pathogens are splash-dispersed onto onion plants where they usually infect plants in the neck region. If there is moisture in the neck, the pathogen can multiply in the neck tissue and move down the neck into the bulb (Fig. 1).
Because most bacterial pathogens of onions are “neck dwellers,” their location makes it difficult for foliar applications of bactericides with contact activity to be effective as the bacteria are protected in the neck. Products with contact activity, including copper bactericides, sanitizers and biological control products, failed to control bulb rot in nine Stop the Rot field trials in California, Colorado, New York and Washington. Georgia was the only place where foliar applications of copper bactericides proved effective, providing 77-88% control.

Stop the Rot scientists theorized that bactericides were effective in Georgia because the dominant bacterial pathogens in that winter area of production are “leaf dwellers” located where contact foliar sprays can contact the bacteria. “Leafdwelling” Pseudomonas spp. and Pantoea spp. dominated in Georgia onion fields surveyed during the cooler winter months, while in all other major onion growing regions “neck-dwelling” Pantoea spp. and Burkholderia spp. were dominant during the hotter summer months when onions are grown.
However, subsequent investigation indicated the most likely reason copper-based bactericides have been ineffective in most regions of onion production is that many of the bacteria in these regions are resistant to copper. Stop the Rot researchers found that 50% of the strains of Pantoea agglomerans from Washington and California, and 90% of the strains of Burkholderia spp. from New York and Pennsylvania for which their DNA was sequenced, have genes that confer resistance to copper. This was confirmed by testing bacterial strains on agar media amended with different concentrations of copper.
Except in Georgia, the Stop the Rot team does not recommend foliar sprays of copper bactericides, sanitizers or biological control products to manage bacterial diseases of onion.


The onion growth stage most susceptible to infection by bacterial pathogens that leads to bulb rot is when the necks are soft, i.e., after the plants reach maximum neck size until the necks have dried (Fig. 2). When onion necks have reached full size and are soft, water can splash into the upright tops, creating favorable conditions for bacterial infection. Furthermore, the dense canopy at this stage means poor air movement between plants, creating a moist microclimate favorable for bacterial disease development.
During the “tops down” stage (lodging), onion neck tissue is dying and, thus, no longer has resistance to infection by bacterial pathogens. Stop the Rot research trials in Washington showed that bulb rot progressively increased for every week that irrigation was continued after 5% lodging. Consequently, the recommendation is to stop irrigation no later than 50% lodging, which can reduce bacterial bulb rot by up to 50% compared to continuing irrigation through 90% lodging. Stopping irrigation sooner can further reduce bulb rot but also may reduce yield.
In regions of onion production more at the mercy of rains, such as New York, if Mother Nature is kind, she will not deliver “rot rain” at maximum neck size through 50% lodging.
If “rot rain” is in the forecast when at least 80% of the onions in a field have soft necks and the foliage still has some green color (moisture), the field may be rolled gently to lay down any upright plants so that rain cannot splash infested soil into the neck (Fig. 3).

Stop the Rot studies in New York showed that rolled onions had 35-57% less bulb rot than non-rolled onions. Rolling onions is especially effective when onion plants are “dying standing up,” which happens when thrips or disease has ravaged the foliage to the extent that it does not have enough weight to lodge properly.
Rolling onions is a way of preventing new bacterial infections from occurring. For plants that are infected but the bacterial infection has not yet moved down the neck into the bulb, protecting open necks from collecting water by rolling the tops could avoid the favorable conditions that accelerate progression of bacterial infection into the bulb.
Green neck tissue contains moisture, which is critical for the bacteria to multiply (reproduce) and move down the neck into the bulb. Bacteria cannot reproduce or move in dry neck tissue. Topping/harvesting when neck tissue is green (moist) creates a wound that is an “open door” for bacterial infection. The greener the neck tissue at topping/harvesting, the greater the risk of bulb rot. A Stop the Rot study in Washington showed that topping/harvesting onions when the foliage had only 5% green tissue and the necks contained 60% moisture significantly reduced bub rot by 65-89% compared to topping/harvesting onions with 90% green foliage and 90% moisture in the neck (Fig. 4).
To win the “rot race,” growers must work to dry green necks before bacteria can multiply in the necks and move into the bulbs. Ways to win the “rot race” include:

• Pull/undercut onions to speed up drying of onion foliage. Ideally, Mother Nature will be kind and deliver warm sunny weather with a light breeze to dry onion foliage rapidly vs. days of rainy weather. Keep in mind, however, pulling/ undercutting onions too early can reduce bulb size and yield.
• Avoid late applications of nitrogen fertilizer (after initiation of bulbing). This promotes vegetative growth and delays maturity, resulting in thick-necked onions that take longer to dry and that dry later in the season when field conditions are less favorable for drying.
• If neck tissue is green, top onions to leave at least 2-3 inches of neck length. This increases the distance that a bacterial infection at the tip of the topped neck must travel to get to the bulb, which “buys time” for the neck to dry down and become impassable for the bacterial infection to spread into the bulb. Georgia studies showed that leaving necks 2-3 inches long when onions were topped with green necks reduced bulb rot by 36-66% compared to onions that were topped with a neck length of
• When onions are harvested with >5% green foliage and >60% neck moisture, they can be cured with heated forced air in a building. Since new bacterial infections can occur at the tips of green necks after topping onions, leaving a 2to 3-inch-long neck and using postharvest curing can quickly dry down the neck tissue to prevent bacterial infections from entering the bulbs. Note, only healthy onions should be cured postharvest with heated air, not those already infected in the necks with bacteria because the warm/hot temperatures used for postharvest curing are favorable for bacteria and accelerate movement of bacterial infection from the neck into the bulb.
• Multiple years of trials in Washington and Colorado showed that applying disinfectants like ozone or hydrogen peroxide to onion bulbs in storage does not prevent any latent infections in the bulbs from developing in storage because these products cannot penetrate the outer, dry wrapper scales to the site of infection in the necks or bulbs. Once bacterial infection has spread into the bulb, there is nothing






By Ching-Ting Feng, Ph.D., Plant Products Division Manager, JH Biotech, Inc.
Beneficial fungi of the genus Trichoderma are now widely recognized as valuable allies in sustainable agriculture. They promote crop growth, suppress harmful diseases, improve fertilizer efficiency and cooperate with other beneficial microbes in the soil. Instead of being a singlefunction inoculant, Trichoderma acts like a multi-tool that strengthens both plants and soil ecosystems.
One of the most visible advantages of Trichoderma is its ability to stimulate plant growth. These fungi release compounds that mimic natural plant hormones such as auxins and gibberellins, encouraging stronger root development and more efficient nutrient absorption. They also help plants regulate stress hormones, which allows crops to better tolerate drought or other challenging conditions. Because roots colonized by Trichoderma can explore soil more effectively, fertilizer inputs are used more efficiently. Farmers often find that with Trichoderma inoculation, crops maintain good performance even when chemical fertilizer rates are reduced. This makes it a practical tool for lowering costs and minimizing nutrient losses to the environment.
Trichoderma is best known for its disease control abilities. It directly attacks harmful fungi by competing for space, producing antifungal enzymes and, in some cases, even parasitizing pathogens. At the same time, it stimulates a plant’s natural immune system, preparing crops to defend themselves more effectively. When combined with other beneficial microbes, such as arbuscular mycorrhizal
fungi (AMF), disease protection is even stronger. Together, they can reduce the severity of root diseases like Fusarium wilt and root-knot nematodes while boosting plant vigor. This integrated protection reduces the need for chemical fungicides, supporting safer and more sustainable crop management.
Trichoderma often works in harmony with AMF and other beneficial soil organisms. These partnerships improve nutrient exchange between plants and microbes, increase root colonization and strengthen tolerance to stress. In vegetable crops such as melons, onions and tomatoes, the combination of Trichoderma with AMF has been shown to increase yields, enhance nutrient uptake and suppress soil-borne pests. This synergy demonstrates that the future of soil health lies not in using one organism alone, but in designing microbial communities that cooperate to benefit the crop.
Beyond pathogens, Trichoderma helps crops withstand environmental stresses such as drought, salinity and heat. It does this by regulating antioxidant systems within plants, stabilizing cell metabolism and reducing the damage caused by excess reactive oxygen molecules. In practice, this means plants stay healthier for longer under stressful conditions, making the best use of limited water and nutrients.
Because Trichoderma can solubilize nutrients like phosphorus and release them into plant-available forms, it plays a direct role in nutrient cycling. It also keeps roots healthier by preventing disease, which ensures plants can take up fertilizers consistently. Studies show that even with lower fertilizer application, crops treated with Trichoderma maintain strong growth and nutrient balance. This makes it a promising tool for farmers aiming to cut costs, meet environmental regulations, or move toward organic and regenerative practices.





UNITED STATES
UNITED STATES


MEXICO
MEXICO
California (661) 699-0055
Lancaster & San Joaquin Valley (661) 978-5342
Irapuato
+52 (462) 220-0453
Torreón, Coahuila (461) 117-3878
Desert Southwest (928) 446-7737
California, New Mexico (661) 300-9109
Colorado & New Mexico (970) 396-9728
Southern California, Arizona (760) 791-0325
Idaho, East Oregon, Utah & Nevada (208) 941-1421
Colorado (208) 550-7733
Idaho, Eastern Oregon, Utah, Nevada, North Dakota (208) 941-1421 (208) 550-7733
Skagit Valley, Washington (360) 941-7503
Rio Grande Valley & West Texas (956) 618-5574
Washington, Western Oregon (509) 820-9887
Texas (956) 618-5574
Torreon +52 (461) 117-3878
Colima, Col. (461) 104-0134
San Luis Potosi (461) 140-9452
Chihuahua +52 (648) 109-1597
Chihuahua (461) 171-9401
San Luis Potosi +52 (449) 196-1848
Tamaulipas (461) 134-2421
Tamaulipas +52 (461) 346-1531
Irapuato, Gto. (461) 546-5792
Colima +52 (461) 104-0134


Another benefit of Trichoderma is its ability to shape the broader soil community. By interacting with other microbes, it encourages the growth of beneficial bacteria and fungi that further support plant health. In some cases, it acts as a “microbiome modulator,” building a more resilient network of organisms that help crops thrive. This not only improves current yields but also contributes to long- term soil fertility and stability.
Trichoderma offers a wide spectrum of benefits: promoting plant growth, improving nutrient efficiency, suppressing diseases, supporting stress tolerance and fostering positive microbial partnerships. Its versatility makes it an essential tool in modern sustainable agriculture. When paired with good fertilizer management and other beneficial inoculants like AMF, Trichoderma helps farmers reduce chemical inputs, stabilize yields under stress and protect soil health for the future. By harnessing the power of this fungus, growers can move closer to a resilient and environmentally friendly farming system.


Author’s note: To learn more about the effects and application programs of Trichoderma products, please visit jhbiotech.com or contact our technical team at info@jhbiotech.com.



Introducing an exciting addition to our long-day onion portfolio.
Mansfield is a recas-type yellow onion variety designed for growers seeking high yield potential and excellent skin retention during long-term storage.
Adapted for long-growing season areas, produces large globe-shaped bulbs with dark brown skin and good uniformity. Its robust root system supports bulb size even under challenging conditions.

This material is provided courtesy of Claudia Nischwitz, Associate Professor and Plant Pathology Specialist, Utah State University.
Occasionally, onion plants are found in the field that are stunted and have started wilting. Most of the time, when they are picked up, they have very few to no roots (Fig. 1). In storage, bulbs start rotting, and small, whitish spots are visible (Fig. 2).
answers on page 24


Ecorobotix continues to refine the detection capabilities of its ARA Ultra High Precision Sprayer available for use in onion production. The company’s Plant-by-Plant artificial intelligence (AI) no longer only distinguishes between crops and weeds, but also identifies classes such as monocots and dicots within crops. This advanced distinction is now available for crops including onions. The algorithm is designed to give growers greater control over weed management, reducing inputs while optimizing each spray application, according to the company. Visit www.ecorobotix.com.

JH Biotech, Inc.’s new soluble seaweed extract, Kelp Star, is a natural plant biostimulant designed to promote healthy plant growth, improve soil health and maximize crop yields. Derived from Ascophyllum nodosum kelp, Kelp Star provides a concentrated source of essential nutrients, minerals and natural growth factors. When applied, the product is said to enhance the plant’s ability to absorb and utilize nutrients, leading to increased vitality and improved resistance to environmental stressors such as drought or temperature fluctuations. Visit jhbiotech.com.



This main-season Northeastern type has strong plant vigor and cold soil germination. Bulbs are globe shaped with good skin quality and great size potential. The variety has strong bolting tolerance and is best suited for fresh and long storage markets.

iAscent is an extra-early Northeastern type that has good pack-outs and earliness, making it ideal for many northern, longday areas. Bulbs are flat bottom shaped with good uniformity for shape and size. Ascent is ideal for transplant programs, with best results obtained under irrigation. It is well suited for fresh and short storage markets.

This medium-early Northeastern type has shown high pack-outs and earliness. Skyline’s maturity makes it well suited for many northern, long-day areas. Bulbs are globe shaped with excellent uniformity. Attractive dark skin color has outstanding retention. It makes size while maintaining an excellent shape and uniformity. The variety is best for fresh and mid-storage markets.

Traverse has early-season maturity in the Pacific Northwest and mid-season maturity in the northeastern United States and southeastern Canada. Traverse has the potential to produce jumbo bulbs. Widely adaptable, it is suitable for fresh and long storage markets. It has high resistance to pink root and Fusarium. Direct seeding is recommended.

Phone: (831) 443-4901
www.takii.com info@takii.com
Extra-early maturing (approximately 85 days), Outlander has excellent uniformity, strong tops, and roots with intermediate resistance to Fusarium. It is ideal for transplants and performs best in the northeastern U.S. and southeastern Canada. Outlander is best suited for fresh and short storage markets.

This early-maturing Northeastern type has shown high pack-outs and earliness. Switchback’s early maturity makes it ideal for many northern long-day areas. Bulbs are globe shaped with excellent uniformity. It is good for transplant as well as direct seeding. Skin color is dark with outstanding retention and thickness. It makes size while maintaining an excellent shape. It is best suited for fresh and midstorage markets.

Airoso has performed well under sprinkler and center pivot due to its vigorous, upright tops. Its early maturity and bolt tolerance make it a great option for an early-to-market hybrid. Airoso has good bulb uniformity, excellent firmness and long-term storage capability.

Montero is an early maturing long-day onion, reaching harvest in about 105 days. It features light brown skin and consistently produces jumbo-sized bulbs. Montero is a dependable option for growers seeking early-season production with high yield potential.

Anillo is a very attractive yellow long-day onion with beautiful, shiny, copper-brown skin and amazing white interior flesh. Its attractive skin, bulb firmness, extremely high uniformity, single centeredness and long-term storage make it an ideal fresh market variety. The 120-day variety is suitable for the Northwest under either sprinkler or drip irrigation.

Rhea is a long-day white onion with a maturity of approximately 122 days. It produces jumbo-sized bulbs with excellent uniformity and bright white color. Rhea stands out for its strong resistance to key diseases and pests, as well as high bolting tolerance, making it a reliable choice for growers.
Phone: (800) 733-9505 www.nunhemsusa.com
Its robust roots and vigorous foliage make Joaquin a highly productive long-day variety. These attributes give Joaquin the ability to withstand some of the harshest conditions from pink root and Fusarium to Iris yellow spot virus. It’s a full-season variety of 130 days maturity. Joaquin is highly consistent in producing jumbo size and larger bulbs with excellent uniformity and medium- to longterm storage potential.

S7210 is a long-day yellow onion that is an early-season variety at around 105 days. The variety is suitable to be grown under drip or furrow/flood irrigation. This variety has excellent eating qualities as being both tearless and sweet.







1972 Silver Spur Place Oceano, CA 93445
Phone: (805) 473-2199 www.bejoseeds.com




Bridewhite offers full-season maturity with a very uniform round shape. Bulbs are bright white and suited for long-term storage. This is a productive variety with upright, dark green foliage adapted to overhead sprinklers.
Hamilton is a classy, exceptionally hard, full-season blocky globe with deep-copper skins. It performs nicely on gravity, drip and overhead irrigation systems. This onion’s extremely longterm storage ability positions it as a leader to satisfy late-market needs, providing high quality.
Yakama is a new opener for the market. It retains a nice skin, develops to very large jumbo sizing and has the ability to cut single centers. It is a very firm 116-day onion, giving shippers a quality early-to-market onion for their customers.

Cesena (FC) - Italy
www.coraseeds.com sales@coraseeds.com
Official distributor: Keithly-Williams Seeds
Phone: (928) 329-7770
o Washington, Oregon:
Josh Carter, (509) 492-0408
o Oregon, Idaho, Nevada, Utah: Joshua Robertson, (208) 473-9437
o Colorado, New Mexico:
Todd Carter, (817) 881-1524
o California:
Bill Rover, (831) 970-0783
Dillon Knight, (661) 868-9315
David Del Papa, (559) 960-1321
o East Coast:
Matt Dicori, (760) 427-7746
This long-day dual-purpose onion is suited for the fresh market and processing. With a unique attractive bronze skin color, the variety does well in long storage.
Fundador is a long-day yellow onion for processing. The variety produces jumbo bulbs with a high single center ratio and high bulb uniformity.

This extra early long-day onion for the fresh market produces jumbo size and high bulb uniformity.
This long-day onion for long storage features an attractive bronze skin color. It offers medium-early maturity, jumbo size and high bulb uniformity.
Zelda is a long-day pink onion for retailers. It features a unique skin color, low pungency and long storability.





Tantrum is an early main-season long-day red onion. Tantrum produces large jumbo bulbs with a rich dark color on the outside with distinctive red rings internally. The deep globe shape and color remain very consistent from bulb to bulb. The top architecture is upright with large vigorous leaves and a refined neck. The root structure remains strong throughout the season. Tantrum stores well for four to six months. It has intermediate resistance to pink root, Fusarium and bolting.

Trident is an early main-season yellow long-day onion with proven wide adaptability in extensive trials in the Northeast, Midwest and western United States. This high-yielding variety produces consistent deep bronze-colored bulbs, large to jumbo in size, with small necks. The outer scale has a nice sheen and is durable, making it a great variety for mechanical harvest. It is highly tolerant to pink root, Fusarium and bolting.

Phone: (208) 459-7451
www.crookham.com
ccoinfo@crookham.com
Caliber is a late-season yellow long-day onion for the western United States known for vigor, disease resistance, and yield and storage capabilities. Caliber is a healthy plant with solid roots and strong, erect tops that assist in providing thrips tolerance and make applications easier. Caliber has a consistent rich bronze scale in supercolossal bulbs with single centers that do very well with mechanical harvest. Caliber has a reputation for storing very well long term. It is highly tolerant to pink root, Fusarium and thrips and tolerant to bolting.

Caldwell is a main-season variety specially bred in Caldwell, Idaho, that has shown wide adaptability outside its hometown. It has performed very well in the western U.S. and other Spanish onion markets. It produces a nice globe onion with a rich bronze scale and demonstrates a high ratio of single centers. The plant has a solid structure with a refined neck, a robust root system and a good disease package. It is highly tolerant to pink root and Fusarium and tolerant to bolting.

Defender is a main-season yellow longday onion for the western United States. It is a vigorous plant with strong, erect tops and roots that give it a strong canopy. Defender has a high percentage of single centers, good ring separation, and uniformity in bulb shape with a rich bronze-colored scale. Defender can store for six or more months, giving growers a high degree of market flexibility. It is highly tolerant to pink root and Fusarium and tolerant to bolting.

Brundage is a later main-season variety that is dazzling white in color with consistent globe-shaped bulbs. It has strong roots and erect tops that help with stress and make spraying easier. It is highly tolerant to pink root and Fusarium and tolerant to bolting.

8269 E. US Hwy. 95
Yuma, AZ 85365
Phone: (928) 341-8494 www.dpseeds.com info@dpseeds.com
Mountain F1 hybrid
Cherry Mountain F1 is a large, brilliant colored, dark-red Grano onion with excellent storage capabilities. This variety produces round bulbs that are uniform in shape with a refined neck. The variety is highly single centered and ideal for the fresh market. Plant in early spring

diamond swan F1 hybrid
Diamond Swan F1 is an early, intermediate/long-day variety with excellent storage capabilities. This variety features a round, very white bulb with a refined neck and is highly single centered.

saffron F1 hybrid
Saffron F1 is a large, yellow intermediate/ long-day Grano onion with excellent storage capabilities. This is an early variety with a refined neck and beautiful dark yellow-bronze skin. This highly single centered variety will do well in North Carolina and in the northern U.S.



Barolo is an early- to mid-season long-day red onion with attractive dark red interior, shiny exterior color and globe shape. Strong against root diseases, and adaptable to overhead, furrow and drip irrigation, Barolo makes a fine choice for the red onion grower’s mid-season crop. Marketing flexibility is increased by Barolo’s three- to four-month storage window.

Tannat is a dark red medium- to late-maturing long-day onion with excellent exterior and interior color. Tops are large, giving Tannat the opportunity to make larger red bulbs. Root system is vigorous, showing good tolerances to both pink root and Fusarium. Expected storage is four to eight months.


www.enzazaden.us r.emch@enzazaden.com

Moonstone is a late, long-day white onion variety known for its uniform, globeshaped bulbs. It offers excellent storage and shelf life potential. The plants are vigorous and upright, maintaining high productivity even under challenging growing conditions. Moonstone consistently delivers high-quality onions with reliable performance.

Delightful is a yellow onion variety that transitions from late intermediate to early long-day maturity. It produces firm, jumbo-sized bulbs that are well suited for mechanical harvesting. With a mild flavor and low pyruvate levels at harvest and throughout storage, Delightful offers excellent eating quality and extended shelf life.

Astoria is a mid-early, long-day yellow onion variety that produces jumbo, round to globe- shaped bulbs with small necks and dark copper-colored skin. It offers excellent storage potential and maintains quality over time. The plants feature upright, healthy tops, strong roots and durable skin, with good bolting tolerance and solid internal flesh characteristics. The variety is well adapted for the Pacific Northwest.


Motley Red is a mid-season, long-day red onion variety featuring strong, upright tops and a robust disease resistance package. It delivers excellent bulb quality with vibrant internal color. With reliable field performance and medium-term storage potential, Motley Red is a versatile choice for growers seeking consistency and visual appeal.

P.O. Box 190
Chualar, CA 93925
Phone: (831) 679-1900
www.gowanseed.com info@gowanseed.com
Colt is a late-season, long-day Spanish onion variety with excellent storage potential. It produces medium to jumbo, globe-shaped bulbs with coppery brown skin that offers outstanding retention. The bulbs are exceptionally firm, and the plants feature strong, upright tops, contributing to reliable performance and ease of harvest. The variety is well adapted for the Pacific Northwest.

Glorioso is a mid-season, long-day yellow onion variety that produces large to jumbo, globe-shaped bulbs. It offers high quality and strong long-term storage potential, making it a reliable choice for both fresh market and extended storage applications. The variety is well adapted to the Northeast and Midwest.



3155 SW 10th Street, Suite 6L
Deerfield Beach, FL 33442
Phone: (954) 429-9445 www.hazera.us.com info@hazera.us.com
Copperstone is an innovative intermediate/Spanish variety. With vigorous and erect growing foliage, bulbs are very firm with a slightly high-round shape, attractive bronze-brown skin and very good skin retention. The variety has high dormancy and is suitable for long storage.

your inbox:

Unisorting brand of UNITEC innovative solutions for the external and internal quality selection of your onions
With ONIONS SORT 4.0 AI and UNIQ ONIONS your onions have more value. Nothing is left to chance thanks to an efficient and complete sorting of the qualities: external and internal quality, in addition to weight, optical size and color.

2468 is a variety growers will appreciate for the early segment. This newly launched variety is ideal for both fresh and processing markets, offering high quality in single centers and uniform, globe-shaped bulbs with attractive scales. It has high pack-out potential and offers flexibility for harvest and storage due to its earliness. The strong tops hold up well to herbicide programs and are suitable for both overhead and drip irrigation, with excellent resistance to bolting.

Richard Navarrete, Technical Sales Representative
Phone: (208) 317-6451
vegetables.bayer.com
richard.navarrete@bayer.com
Formerly trialed under the name SVNW1672 and newly launched, this variety provides high yields of uniform, globe-shaped bulbs with excellent scale coverage, color and retention. The scale quality, combined with a very firm bulb, provides long-term storage potential. Nice, erect tops are suitable for both overhead and drip irrigation systems.

Crusher is a main-season yellow onion that delivers high yield potential with quality scale and single centers. It has great agronomics for everyday packer and processor needs.

Hatchet is a full-season yellow onion that produces high percentages of single centers with a classic globe shape. It has vigorous agronomics with high yield potential.

Red Garcia is named for its rock star taste and performance. With its high yield potential, classic globe shape and single centers, this low-pungency red onion is ideal for the foodservice market.

Tessenderlo Kerley Inc. has acquired Eastman’s U.S. and Canadian crop protection metam sodium (CLRTM 42%) and metam potassium (KLRTM 54%) product labels. The acquisition creates a stronger, more accessible product line designed to help growers protect their crops, improve soil health and maximize yield potential, according to Tessenderlo Kerley. The company says its distribution network and field support teams will ensure U.S. and Canadian growers have timely access to metam products and expert guidance on application best practices. Tessenderlo Kerley also plans to launch updated stewardship and training programs focused on safe handling, regulatory compliance and integrated pest management.

Volm Companies has signed a new dealership agreement with Flikweert Vision, a Netherlandsbased provider of equipment for the onion and potato industries. The partnership will help Flikweert expand its international footprint and allow Volm to expand its equipment portfolio with the addition of Flikweert’s Divider and Quality Grader.
The Divider is an optical sorting machine that separates foreign objects from field crops. Using AI technology to process up to 120 tons per hour, the machine is built to optimize product flow, resulting in less wear, product damage and waste down the line.
The Quality Grader uses a combination of AI and advanced camera technology to sort up to 20 tons of product per hour.
These onions have been damaged by acarid bulb mites (Rhizoglyphus species) (Fig. 3). The mites are small, pearl shaped and cream colored. They can be seen with the naked eye (small, white spots on bulbs). The mites usually survive in decaying plant debris in the field. Thus, fields with high organic matter may have higher mite populations.
While feeding on the outer layers of the bulb (Fig. 1), the mites cause direct feeding damage. In addition, the feeding creates wounds that are entrance points for fungal and bacterial bulb rot pathogens that result in rot starting at the base of the onion (Fig. 2). In direct-seeded onion fields, the mites can sever the radicle before the onion seedling gets established, resulting in stand loss. Symptoms of feeding damage in the field are similar to feeding by seedcorn maggots.

In storage, the mites can move from bulb to bulb if no cold storage is available.
In addition to onion, the mites can infest other bulb and tuber crops, including garlic and some cut flowers like tulips or freesia.
There are few management options for bulb mites. Good cultural practices that allow for good growth after cool, wet conditions in the spring allow onions to grow out of injuries caused by bulb mites. There are no effective acaricides.











— Albert Einstein

The voice of America’s onion industry in Washington D.C. https://bit.ly/JoinNOA

We’ve been breeding onions for more than 40 years, and offer close to 50 different varieties across 56 countries around the world. So yeah, we know a thing or two about onions. Be a voice — not an echo.
















seed treatments provide early season disease and insect protection for young onion crops. Seed Dynamics applies the protectant to the seeds themselves, through a safe and controlled delivery. It works at the most critical time — during germination and seedling emergence — so your seeds can thrive, while fending o threats of early damage. Get a hero from Seed Dynamics , the Seed Preparation Professionals. Call us at 86 6.321.9747 or choose a dealer listed above. Visit our Website at SeedDynamics.com! When onion seed and seedcorn maggots threaten young crops, our heroes come prepared. FarMore FI500 and Spinosad/Lumiverd












